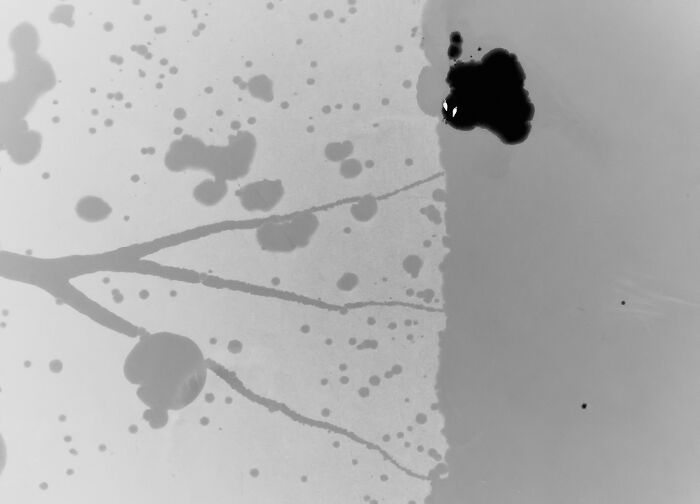
Black And White: "Winter Swans" By Tomasz Sczansny (Bronze)

Best Photos Of The Bird Photographer Of The Year 2022 Awards (35 Pics)
InterviewI believe most of you will agree that birds are fascinating. I mean, they can fly! And not only that. Have you ever seen the Vogelkop superb bird-of-paradise's dance, observed a flock of flamingos gracefully standing on one leg, or witnessed an eagle hunt? If that is not enchanting, I don't know what is.
For all the winged creature lovers out there, we present to you the winners of The Bird Photographer of the Year, 2022! This global photographic competition is entirely dedicated to avian photography and is open to a wide range of photographers, "a hardened pro, a keen amateur with the latest kit, or simply a hobbyist with a cameraphone or small compact camera."
This year, the jury of leading experts had a hard task to select the most incredible photos celebrating bird life from around the world out of over 20,000 submissions. Scroll down to meet the winners!
If you're interested in seeing the best images of previous competitions, you can find them by clicking here, here, here, here and here.
More info: birdpoty.com | Instagram | Facebook | twitter.com
This post may include affiliate links.
9-13 Years: "Droplets" By Parham Pourahmad (Gold)
Established in 2016, Bird Photographer of the Year was founded to promote birds and conservation through images. They are partnered with the charity Birds on the Brink, to whom they provide vital funding. This funding supports grass-roots conservation projects for birds around the world. Birdpoty images, books, and exhibitions all have a conservation thread woven carefully through the images, showcasing important messages to the viewing public.
Bird Behaviour: "Face-Off" By Kathy Wade (Highly Commended)
Attention To Detail: "Beads Of Diamonds" By Sue Dougherty (Bronze)
Bored Panda got in touch with an assistant manager at Birdpoty and nature photographer, Audrey Granger, to get to know more about this year's competition. She revealed that they have seen a great range of creativity from photographers, with exciting variations in lens choices, styles, and subjects. "This makes for a broad and varied exhibition."
The 2022 competition's judges included Mark Carwardine, Sergey Gorshkov, Li Ying Lou, David Lindo, Melissa Groo, Erin Ranney, Andrew Cleave, Paul Sterry, Myles Archibald, Will Nicholls, Majed Al Za’abi, Denise Ippolito, Tin Man Lee, Alejandro Prieto, Rathika Ramasamy, Jamie McPherson, and Hans Ngoteya. The full list of judges for the 2023 competition can be found here.
Urban Birds: "Gonzo" By Laszlo Potozky (Silver)
I don’t know why, but this one makes me a little sad that this is where Gonzo lives. But, he is adorable.
Creative Imagery: "Smokescreen" By Kathryn Cooper (Highly Commended)
According to Audrey, the judges looked for technical excellence, images that have interesting compositional elements, and images that remain true to what the photographer saw when taking their photos. They were also looking for unique images that tell a strong story, or show birds in a new and perhaps unseen way.
Black And White: "Between Two Worlds" By Henley Spiers (Gold)
14-17 Years: "Sunset" By Thamboon Uyyanonvara (Bronze)
The overall Winner of the Bird Photographer of the Year 2022 is "Rock Ptarmigan Flight" taken by Erlend Haarberg. His image also won Gold Award in the Birds in the Environment category. Haarberg wins the top prize of £5,000 and the prestigious title.
9-13 Years: "Shadows" By Andrés Luis Domínguez Blanco (Silver)
Birds In The Environment: "Free As A Bird" By Mario Suarez Porras (Bronze)
Birds In The Environment: "Meeting The Giant" By Tomasz Szpila (Highly Commended)
14-17 Years: "Pied Avocet Chick" By Tamás Koncz-Bisztricz (Silver)
Bird Behaviour: "Waxwing Silhouette" By Simon D'entremont (Bronze)
Best Portrait: "Colourful Meal" By Ponlawat Thaipinnarong (Highly Commended)
Birds In Flight: "Starling At Night" By Mark Williams (Silver)
I have a baby starling as a pet, I raised her from a chick (It is legal to own a starling in the us because they are considered pests) and they get a really bad reputation for pooping on things, but in reality they are really sweet :)
It's not that their pests, it's that they are highly invasive, this is a much better environment for them than their native environment, so they decimate our wild native populations of birds.
Load More Replies...Wonderful picture. It isn't easy to shoot at high speed shutter and in low light
Urban Birds: "In The Shadow Of Indusry" By Brian Matthews (Highly Commended)
Best Portrait: "The Doting Couple" By Richard Flack (Bronze)
Purple-crested Turacos from South Africa. Males and females have the same plumage.
Overall Winner And Bird Photographer Of The Year 2022: "Rock Ptarmigan" By Erlend Haarberg
Black And White: "King Penguin Portrait" By Rafael Armada (Highly Commended)
Best Portrait: "For The Love Of Birds" By Thomas Wester (Highly Commended)
Creative Imagery: "Van Gogh's Storks" By Petro Katerynych (Gold)
Bird Behaviour: "Which One Is First?" By David Pattyn (Highly Commended)
OK, I had to look this up because those babies are awesome. These are Great Crested Grebes, were almost extinct in the UK (because feathered hats), but they are making a comeback. And the chicks are rock stars! Great-Cres...feb0f4.jpg 
Birds In Flight: "Attack!" By Damian Kwasek (Highly Commended)
Birds In The Environment: "Beacon In The Swamp" By Raymond Hennessy (Highly Commended)
Birds In Flight: "Schalow's Turaco" By Aaron Baggenstos (Bronze)
The turaco-family are the only birds with *true* green pigment. Usually, what we perceive as green is some shade of yellow, paired with the Struktur of the feathers that breaks the light in certain ways. The red pigment is unique, too - other birds have their red from carotinoid pigments. Not these here, though.
Best Portrait: "Colourful Meal" By Ponlawat Thaipinnarong (Highly Commended)
8 Years And Under: "Hoot Are You?" By Arjun Jenigiri (Gold)
"8 years and under" no one would let me even near an expensive camera. Wow, those kids are amazing!
Attention To Detail: "Sleeping Beauty" By Andy Pollard (Gold)
Bird Behaviour: "Tidying Up" By Lucca Rodriguez Amorim (Highly Commended)
I believe that this is a male bird, collecting & using blue objects, to build his nest, attract females, dance, and find a mate.
Urban Birds: "The Owlet And The Dump" By Kerry Wu (Bronze)
Birds In Flight: "Into The Sunset" By Patrick Coughlin (Highly Commended)
Black And White: "A Seabird Summer" By Rachel Bigsby (Highly Commended)
Black And White: "The Guardian Of Mordor" By Paweł Smolik (Silver)
Black And White: "White Tern In Black" By David Stowe (Highly Commended)
Bird Behaviour: "Fight" By Erlend Haarberg (Highly Commended)
Wow! How was this taken?… Oh, I just realized that’s ice??? At first it looked like these birds were way up in the sky…
Creative Imagery: "Sandhill Crane Flight Air Show" By Wei Lion (Bronze)
8 Years And Under: "The Poser" By Ameyaa Akhil Vinayak (Silver)
Birds In The Environment: "Flamingo Island" By Paul Mckenzie (Highly Commended)
Urban Birds: "Sunrise In The Old Farmhouse" By Richard Peters (Highly Commended)
Birds In Flight: "Snowy Flight" By Liron Gertsman (Highly Commended)
9-13 Years: "Hop, Skip And Jump" By Achintya Murthy (Bronze)
Birds In Flight: "The Sublime Aviator" By Ruth Hughes (Highly Commended)
Bird Behaviour: "Ow! That Hurts" By Nicholas Tian (Highly Commended)
Bird Behaviour: "Hummingbird Hideaway" By Liron Gertsman (Highly Commended)
Bird Behaviour: "Guillemot Swimmers" By Henley Spiers (Silver)
14-17 Years: "Facing The Storm" By Levi Fitze (Gold)
9-13 Years: "The Look" By Parham Pourahmad (Highly Commended)
Birds In Flight: "Silo Mural" By Raoul Slater (Gold)
Urban Birds: "Over The City" By Ammar Alsayed Ahmed (Gold)
Bird Behaviour: "Brine Fly Buffet" By Mary Anne Karren (Highly Commended)
Bird Behaviour: "Full Contact" By Gabor Baross (Highly Commended)
Birds In The Environment: "Flamingo In The City" By Faisal Alnom (Highly Commended)
8 Years And Under: "Beautiful Tracks" By Malia Piecha (Bronze)
Urban Birds: "Orange Eyes" By Simone Baumeister (Highly Commended)
Bird Behaviour: "Jumping To Impress" By Markus Varesvuo (Highly Commended)
Best Portrait: "Wart Head" By Leander Khil (Highly Commended)
Best Portrait: "The Lady Of The Shore" By Mario Suarez Porras (Highly Commended)
Best Portrait: "Strut Performer" By Ly Dang (Gold)
Black And White: "The Perch" By Andrew Skinner (Highly Commended)
Birds In The Environment: "Kaleidoscope" By Paul Mckenzie (Silver)
Best Portrait: "Rainforest Wanderer" By Lincoln Macgregor (Highly Commended)
Best Portrait: "Puffin Love" By Brad James (Silver)
Bird Behaviour: "Duelling On The Lek" By Peter Ismert (Gold)
Birds In The Environment: "Storks On The Cliff" By Nuno Cabrita (Highly Commended)
Attention To Detail: "Mating Glow" By Kerry Murphy (Highly Commended)
Attention To Detail: "Crazy" By Isabella Chowra (Silver)
Creative Imagery: "Fishy Business" By Janine Lee (Silver)
Black And White: "Winter Swans" By Tomasz Sczansny (Bronze)
Creative Imagery: "Out Of Signal" By Severin Fromyr (Highly Commended)
All of these are stunning. I didn’t leave comments because I’d run out of things to say. The photos by the young people are beyond amazing. Incredible talent I hope they get to foster.
All of these photos are such good quality, I wish I could capture images as good as these with a smartphone! 😂 Also, I LOVED Black And White: "Between Two Worlds" By Henley Spiers, that is STUNNING!
All of these are stunning. I didn’t leave comments because I’d run out of things to say. The photos by the young people are beyond amazing. Incredible talent I hope they get to foster.
All of these photos are such good quality, I wish I could capture images as good as these with a smartphone! 😂 Also, I LOVED Black And White: "Between Two Worlds" By Henley Spiers, that is STUNNING!

 Dark Mode
Dark Mode 

 No fees, cancel anytime
No fees, cancel anytime